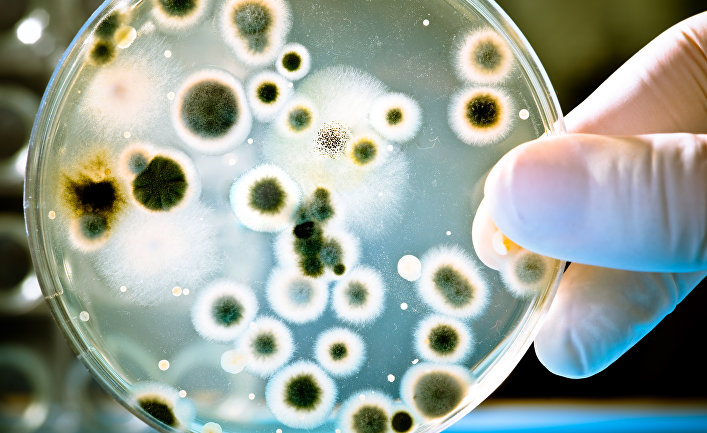
Турецкие ученые открыли 60 новых видов бактерий в шести странах

Турецкие ученые открыли 60 новых видов бактерий в шести странах
Заведующий кафедрой молекулярной биологии и генетики факультета искусств и наук Самсунского университета «19 мая» заявил, что его коллектив открыл 60 новых видов бактерий. Почему это очень важный шаг для науки и как он повлияет на развитие медицины — в материале Haber7.
Заведующий кафедрой молекулярной биологии и генетики Самсунского университета «19 мая», профессор, доктор Невзат Шахин и его коллектив открыли 60 новых видов бактерий. Ожидается, что после идентификации и наименования вновь обнаруженные виды войдут в научную литературу.
Заведующий кафедрой молекулярной биологии и генетики факультета искусств и наук Самсунского университета «19 мая», профессор, доктор Невзат Шахин (Nevzat Şahin) и его коллектив открыли 60 новых видов бактерий по итогам исследований образцов, взятых из почв и озер на территории Турции, Туркмении, Кипра, России, Нигерии и Индии.
Ожидается, что после идентификации и наименования виды, обнаруженные в результате двухлетней работы, войдут в научную литературу.
Профессор, доктор Шахин отметил, что открытые виды бактерий — это важный шаг и для открытия новых лекарств и антибиотиков. По его словам, ученые стараются создать добавленную стоимость из генетических ресурсов Турции.
Шахин рассказал, что организмы, над которыми они работают, в основном являются организмами группы актинобактерий. К этой группе относятся микроорганизмы, из которых получают сотни широко используемых в медицине антибиотиков.
Шахин продолжил: «Обнаруженные организмы мы изолируем от их естественной среды обитания, а именно почвы, донных отложений, воды, растительности, тканей, корней. Затем идентифицируем изолированные организмы, применяя тесты международных стандартов. Если среди идентифицируемых нами микроорганизмов есть новые виды, мы присваиваем им названия в соответствии с правилами международной номенклатуры. Далее публикуем статьи в респектабельных журналах и вводим эти виды в научную литературу».
«Мы также проводим исследования по открытию новых лекарств и антибиотиков»
Говоря о том, что за последние два года было открыто 60 новых видов бактерий, Шахин отметил: «Большинство этих видов бактерий по своим генетическим характеристикам являются источником антибиотиков. Мы также проводим исследования по открытию новых лекарств и антибиотиков, связанных с ними. Нашу работу по созданию новых лекарственных препаратов поддержало государство. У нас есть еще одно исследование, в котором за последний год были получены важные результаты в этой связи. Кроме того, есть и другие коллективы, работающие над открытием новых лекарств, связанных с организмами, которых мы идентифицировали и назвали. Мы будем продолжать усилия в направлении создания добавленной стоимости из генетических ресурсов нашей страны».
Comments are closed.